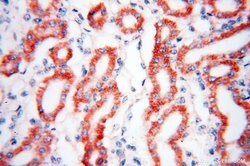
ANT1/2 Rabbit anti-Human, Mouse, Rat, Polyclonal, Proteintech 150 &mu;L;

missing translation for 'onlineSavingsMsg'
Learn More
Learn More
ANT1/2 Rabbit anti-Human, Mouse, Rat, Polyclonal, Proteintech
Rabbit Polyclonal Antibody
Brand: Proteintech 17796-1-AP-150UL
This item is not returnable.
View return policy
Description
This antibody recognizes both of ANT1 and ANT2. The predicted molecular weight of ANT1/2 protein is around 32 kDa. While 60 kDa protein can also be observed, which has been proposed as the dimmer of ANT1/2.
Adenine nucleotide translocator (ANT) and the voltage-dependent anion-selective channel proteins 1 and 2 (VDAC1 and VDAC2) are components of the permeability transition pore complex (PTPC) of the mitochondrial inner and outer membranes, respectively. Formation of PTPCs, the subsequent dissipation of mitochondrial inner membrane potential and release of cytochrome c through the outer mitochondrial membrane are critical events in the early stages of apoptosis. Bax, a proapoptotic protein, has been shown to act upon ANT to induce the dissipation of mitochondrial inner membrane potential. ANT1 has a role in the maintece of mitochondrial DNA by catalyzing the exchange of ADP and ATP across the mitochondrial inner membrane.Specifications
| ANT1/2 | |
| Polyclonal | |
| Unconjugated | |
| SLC25A4 | |
| 2F1, AAC2, ADP,ATP carrier protein 2, ADP/ATP translocase 2, ANT 2, ANT1/2, SLC25A5, T2, T3 | |
| Rabbit | |
| Antigen Affinity Chromatography | |
| RUO | |
| 11739, 11740, 25176, 291, 292, 85333 | |
| -20°C | |
| Liquid |
| Immunohistochemistry (Paraffin), Western Blot | |
| 0.45 mg/mL | |
| PBS with 50% glycerol and 0.02% sodium azide; pH 7.3 | |
| P05141, P12235, P48962, P51881, Q05962, Q09073 | |
| SLC25A4, Slc25a5 | |
| ANT1/2 Fusion Protein Ag11956 | |
| 150 μL | |
| Primary | |
| Human, Mouse, Rat | |
| Antibody | |
| IgG |
Product Content Correction
Your input is important to us. Please complete this form to provide feedback related to the content on this product.
Product Title
Spot an opportunity for improvement?Share a Content Correction